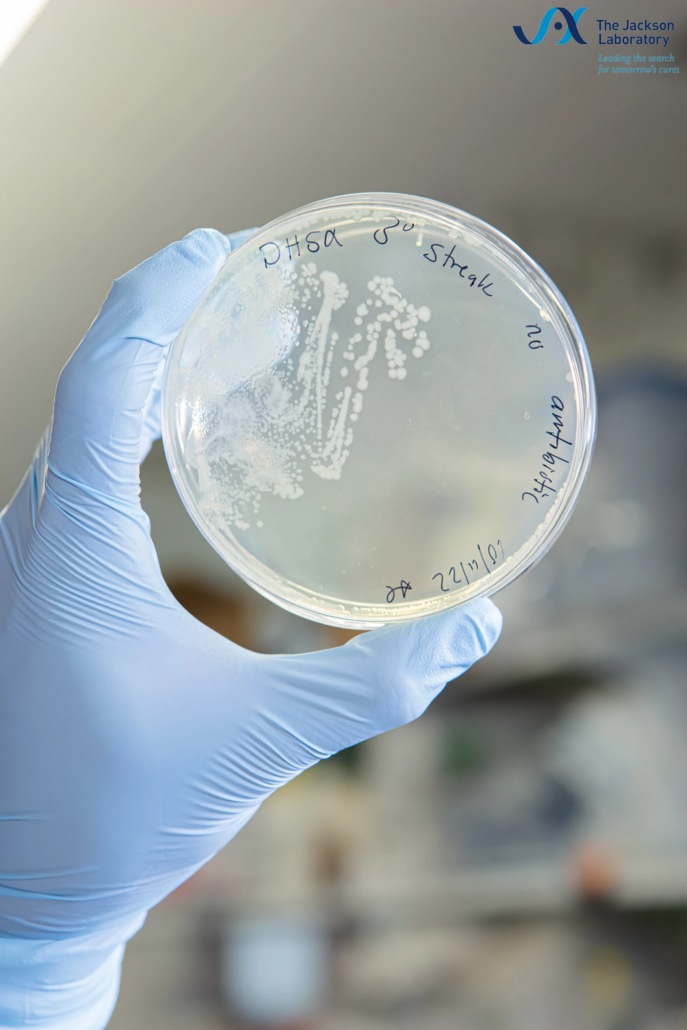
Laboratory Sample Handling Photography Petri dish handling technique - Scientific laboratory photography by Camarda Visual Studio

Visual Identity & Web Design for Scientific Research
For several years, Camarda Visual Studio has provided scientific web design and portrait photography for the Ucar Laboratory at The Jackson Laboratory for Genomic Medicine, creating complete website solutions to support the laboratory’s communication and recruitment needs.
Scientific Web Design for Computational Biology Research
The Ucar Laboratory needed a modern, maintainable website to replace an earlier version built years ago. Camarda Visual Studio created the site from scratch, designing a platform that organizes complex research outputs, highlights publications with an active filtering system, and provides intuitive navigation for postdoctoral candidates and collaborators.
The website serves as a tool for recruitment and research visibility. Built with flexibility in mind, the site accommodates regular updates as the team publishes new work and welcomes new team members. Camarda Visual Studio maintains the site on an ongoing basis, implementing updates as needed.